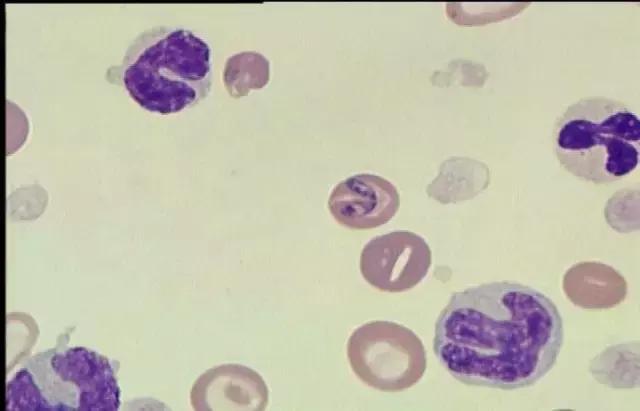
焦虫病死亡周期,焦虫病早期

它是主人最爱的孩子,从两三个月开始就与主人相伴。
它也像其他毛孩子那样爱调皮捣蛋,撕床单、咬桌脚,爱叼杯子然后打碎。
它会十八般武艺,坐下、握手、打滚、卖萌、撒娇,竟然还会在卫生间尿尿和粑粑。
它最喜欢跳到床上,霸占主人的床,然后偷偷放屁熏走主人自己独占大床。
但是,这一切它都不会做了,因为它已经离开了这个世界......
虽然还在假期,但是小编我今天不得不的分享这个悲伤的故事。这是一个活生生的故事,而且就发生在我们宠约大家庭的一员——拉拉的身上。希望这个故事在第一时间能给广大狗狗家长敲响警钟,避免类似的悲剧重演。
《拉拉日记》
2016年2月27日,今天天气不错。我们全家出动,怀着无比激动的心情前往机场接我们的狗宝宝。第一时间打开航空箱,看到狼狈不堪的你,瑟瑟发抖。虽然你臭臭的,我还是舍不得把你继续放在航空箱,赶紧转移放在车后排,暖气开大。你似乎很胆小,一直躲在姐姐身子后面。

回家后你熟悉了环境,很开心的。但是你很有个性和脾气。放你出来自由活动的时候,你表现出来不一般的破坏力。关进笼子你又叫个不停,是不是笼子太小?好吧!换大号,反正你到时候长大也得换。
你长的很快,短短不到一个月的时间,个头长了不少,我高兴同时又有点小忧郁,我怕你长大,听说狗狗只能活十几年。

4个月零19天,你又长大了一些。精力旺盛,各种破坏,让我自豪的是你学会了在卫生间大小便,所以撕壁纸、咬桌子、从餐桌上叼杯子打碎,我就暂且忍忍吧!
转眼间你已经半岁了,散步是你我的爱好,你也因此结识了很多好朋友。你真的很聪明。不过有一点我真的不明白,你为什么总喜欢和男狗狗疯玩?

你也学会了很多本领,比如握手、坐下、打滚,还会撒娇、卖萌,作为男子汉,这样,真的好么?
我在做饭的时候你喜欢偷偷开厨房门,看看有没有可能从我这里要点好吃的,或者从垃圾桶偷偷捡点美味。

你总喜欢趁我不注意,偷偷跳上床,趴着我的枕头,偶尔还会放臭不可闻的屁,竟然还嫌弃我刚刚洗过的脚。太不公平了,我的脚不臭好吧!

可是,美好的日子总是那么短暂。
8月3号,噩梦的开始。由于小区一家宠物店新开张,我和你出去逛顺便溜达到那里,心血来潮说你没做过内驱虫,就买了体内驱虫药。店主说这是拜耳驱虫,进口的,我信了,看也没看就把拆开包装的药接了过来,回家给你喂了,之后两天你大小便正常并未见任何虫子排出来。可是渐渐的你开始吃饭少喝水少了,但是遛弯精神很足,我也就没在意,以为是驱虫药影响饮食。
可是一周过去了,情况还是没见好转,你的体重由75斤急剧降至66斤。我非常着急,去问宠物医生,医生说精神很好,让回家观察。我到买药的那家宠物店,看了药才发现居然是国内的内虫清!网上根本查不到这个药,店主保证说这个药没问题,只是从厂家发错药。我去!药也可以乱发?只能继续观察,你还是不咋吃,时好时坏。

9月6号我前往离家109多公里的省城给你看病,做了化验,说只是轻度贫血,给开了进口的药,回家吃了5天,情况依然不见好转。
9月17号你牙龈有些白了,在另外一家新开宠物店做了焦虫,报告阴性,我松了一口气:还好不是焦虫!你刚好到了发情期,又有内驱虫药事件,所有人都认为这些因素影响,直说精神还好,就是回家懒洋洋不动,应该没事。

一个*友狗**告诉我当地医院不可靠,让我赶紧去省城,我听从劝告,第二天赶往省城另一家医院,化验提示焦虫阳性。我还有点小庆幸,听说焦虫病可以治好的,回家治疗吧!回家当天就给了比利时焦虫针,没有反应,很好。20号给第二针,当天没反应。21号晚上你开始出现抽搐,口吐白沫,我立马请当地医生急救,5分钟后缓解了。
22号下午你已经失明。我问当地医生,他说可能神经系统症状,站不稳而已。这个时候的你已经连走路的力气都没有了,我很害怕,再次送往省城医院,并要求住院,当天没有发生抽搐。我们回家了,只留你一人在医院。第二天医院发来视频,说你情况稳定,不让我们再跑了,可是我依然放心不下,从来没有离开过我的你会不会在失明的状态下更需要亲人的呵护,我毅然赶往医院看望。

当我到达医院就听见你痛苦的嚎叫,我的心都碎了,我冲上楼抱着你,呼叫你的名字,不停的抚摸你呼唤你,可是你还是不停的抽搐嚎叫。医生让我出去,避免你情绪激动,可是在门外听到你撕心裂肺的叫声我的眼泪止也止不住,我还是抱着你,喊着你的名字。医生给你打了安定,希望能止住你的抽搐。
我请医生全力救治,把焦虫针的毒解了,哪怕输血、透析。医生说没有解毒方法,只能靠自己代谢。我只能选择回家,既然没有办法,我不如回家自己护理,最起码能安心些。下午到家,我求助中药治疗,到处托人买来安宫牛黄丸,希望这是神药,能够就你一命,我就这么抱着你,在阳台......

我抱着你,和你并排睡在阳台,你盖着你的小被子,我和衣而卧搂着你的脖子,抽搐的时候我什么也做不了,只能叫你。感觉如此无助,只能在心里祈祷,扛过这一阵下一阵就会好!药终于来了,我喂你吃下安宫牛黄丸,抽搐还在继续。
大约过了十几分钟,抽搐停止了,我庆幸这样是不是就管用了?我去送姐姐上学,让爸爸在家看着你。回家时,感觉你异常安静,走到你跟前,发现你没有呼吸起伏,摸不到脉搏,听不到心跳,试不到呼吸,我立即拔掉嘴里的磨牙棒,给你做胸外按压,可是你就是一动不动......
拉拉回来!可是你连一声叹息都不给我,我以为我在做梦,就这样抱着你,我希望会有奇迹,说不定你会叹息一声告诉我你回来了。可是没用了,怪我自己,没有照顾好你,多好的一个孩子,怎么会?我抱着你一直到从你呼吸停止的19点左右到晚上2点,你的身体慢慢由温暖到冰冷,由柔软到僵硬,看着你你的眼睛陷了进去,我给你暖脚,可是怎么也暖不了......
生前调皮可爱的拉拉
你走后我吃不下也喝不下,以泪洗面,无法上班,家里到处都是你的影子。饭吃两口,眼泪就流下来了。你坐在我身边问我要吃的样子,坐在我床旁的样子,喊我起床的样子,我再也看不到了,我再也摸不到了你温暖的爪子,软软的毛,看不到你亮亮的眼睛,黑黑的大鼻头,可爱的笑了
......
上个月,才半岁多的拉拉因为“焦虫病”就离开了这个世界。大家肯定想知道,究竟什么是“焦虫病”?
焦虫病
焦虫病, 是蜱虫携带的一种血液原虫,专门寄生在动物的血红球中,引起嗜睡、厌食、发烧、喘息、呕吐、便秘、下痢及其他更严重的症状,尤其以严重贫血和高热为特征。
拉拉妈说,一直对拉拉驱虫方面没有重视,拉拉到家半年多,喜欢到草丛里大小便,只进行过三次体外驱虫,还发现过一次蜱虫,而唯一的体内驱虫没想到却成为了拉拉病情严重的导火线。拉拉一直胃口不好,而后渐渐贫血,很有可能是因为没有按时体外驱虫从而寄生了蜱虫,而蜱虫将焦虫带入了它的体内,加上误用药导致中毒而亡。

关于焦虫病的治疗,所用的抗寄生虫药本身就含有一定的毒性,所以在用量和用时都特别严格,稍有不慎反而造成狗狗中毒。
焦虫病的发生,最主要就是因为没有做好驱虫而造成的。小编特地查了驱虫方面的相关资料,希望更多的狗狗家长们能对狗狗驱虫有更多的了解和重视。
为什么要驱虫
平时我们会有遛狗的习惯,狗狗经常趁主人不注意拾捡不干净的东西吃掉,或者是喜欢钻到草丛里玩耍。其实这样长此以往,是很容易感染寄生虫的,所以给狗狗驱虫非常重要。

体内驱虫
一、体内驱虫的原则
药虽然可以治病,但是药三分毒,因此尽量在减少狗狗肠胃刺激的情况下选用驱虫药,这就需要注意给狗狗体内驱虫的时间。
1.幼犬的体内驱虫每一个月进行一次;
2.成犬的体内驱虫每三个月进行一次;
3.由于春夏两季是寄生虫多发季节,经常出去遛的狗狗应该经常到正规医疗机构检查体内寄生虫情况,按照病情服用驱虫药。

二、体内寄生虫的种类
体内寄生虫比较多,对狗狗的危害很大。主要包括:蛔虫、绦虫、心丝虫、弓形虫、球虫、滴虫、钩虫等
三、靠谱的体内驱虫药
我们推荐的品牌:
1.拜宠清(来自德国拜耳公司)

2.犬心保(来自法国梅里亚公司)

(选用犬心保进行体内驱虫,一定要提前到医院检查狗狗是否有心丝虫,如果有则禁用)
在给狗狗服用体内驱虫剂,一定一定要按照规定的剂量来。不然,稍有多量,会造成狗狗中毒。
体内驱虫的方法
为了减少驱虫药对狗狗肠胃上的刺激,在给狗狗喂药时,最好选在狗狗吃过东西后的两小时以后,这个时候喂药比较好混在食物中被消化掉,同时减少狗狗呕吐的情况,更好的发挥药效。

体外驱虫
狗狗与外界接触的机会相对于其他宠物来说相对多一些,不过在看着狗狗在草丛里钻来钻去时别顾着开心,记得按时进行体外驱虫哦。狗狗的被毛比较长,那些寄生在它们身上的虫子我们不容易发现,有些寄生虫可能还会传染给人类,所以定期的为狗狗体外驱虫相当重要。

一、体外寄生虫的种类
体外寄生虫可以分为皮肤内和皮肤外寄生虫:
1.皮肤外寄生虫:蜱虫、虱子、跳蚤等
2.皮肤内寄生虫:螨虫

二、体外驱虫的原则
1.一般来说每一个月给狗狗进行一次体外驱虫;
2.体外驱虫可以和疫苗同时进行,一般不会有什么影响。
3.经常出门遛的狗狗,尤其是爱钻草丛或者爱和其他狗狗玩,体外驱虫可以频繁一些,甚至在春夏两季可以选择在狗狗出门前给它用上体外驱虫剂,出门不容易被寄生虫干扰啦。

三、靠谱的体外驱虫药
体外驱虫药有滴剂和*剂喷**,大家可以根据自己的需求选用。
狗狗身上如果有外伤,不能使用体外驱虫药哦。
我们推荐的品牌:
1.福来恩(来自法国梅里亚公司)
福来恩滴剂

福来恩*剂喷**

2.大宠爱(来自美国辉瑞公司)

四、体外驱虫的方法
1.使用滴剂时,正确的方法是先拨开宠物肩胛骨中间处毛发直到露出皮肤,把产品滴到宠物肩胛骨中间处皮肤上的一个点,而非毛发上,因为药剂需靠皮肤油脂扩散至全身,并保证滴尽所有剂量。

2.虽然有些药剂是可以防水,为取得最佳效果,建议使用后2天避免用洗浴液洗澡,保证药剂贮存到位,使用时确认犬猫毛发已经干燥。
小编说这么多,都是为了拉拉的悲剧不再发生在任何家庭中。总的来讲,这个悲剧告诫我们:
1.狗狗的体内体外驱虫一定要重视;
2.医疗机构和药物的选择一定要慎重。
3.药物的购买一定要通过可靠的渠道,服用剂量要慎重;
4.不要擅自给狗狗用药,狗狗的解毒能力与人体不一样。